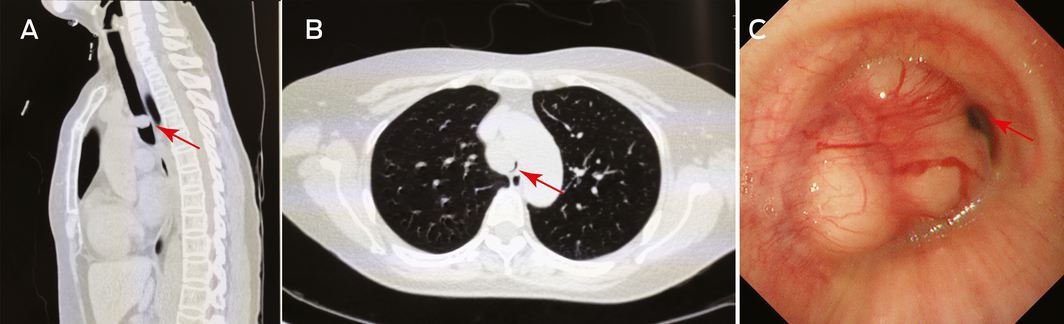

The full article is accessible to AMA
members and paid subscribers.
Login to MJA or subscribe now.
- 1. Karamustafaoglu YA, Yanık F, Yoruk Y. Palliative treatment of recurrent tracheal pleomorphic adenoma 10 years after segmental resection using the endobronchial shaver. Clin Respir J 2020; 14: 495–497.
Online responses are no longer available. Please refer to our instructions for authors page for more information.





No relevant disclosures.